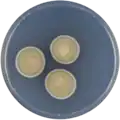
Aspergillus microcysticus growing on CYA plate

Aspergillus microcysticus
| Aspergillus microcysticus | |
|---|---|
| Scientific classification | |
| Kingdom: | Fungi |
| Division: | Ascomycota |
| Class: | Eurotiomycetes |
| Order: | Eurotiales |
| Family: | Aspergillaceae |
| Genus: | Aspergillus |
| Species: | A. microcysticus
|
| Binomial name | |
| Aspergillus microcysticus | |
| Type strain | |
| ATCC 16826, BCRC 33360, CBS 120.58, CCRC 33360, IMI 139275, NRRL 4749, QM 8158, WB 4749[3] | |
Aspergillus microcysticus is a species of fungus in the genus Aspergillus.[1][4] Aspergillus microcysticus produces aspochalasin A, aspochalasin C, aspochalasin D, and the antibiotic asposterol.[5][6][7][8][9]
Growth and morphology
A. microcysticus has been cultivated on both Czapek yeast extract agar (CYA) plates and Malt Extract Agar Oxoid® (MEAOX) plates. The growth morphology of the colonies can be seen in the pictures below.
-
Aspergillus microcysticus growing on CYA plate
Aspergillus microcysticus growing on CYA plate -
 Aspergillus microcysticus growing on MEAOX plate
Aspergillus microcysticus growing on MEAOX plate
References
- ^ a b "Aspergillus microcysticus". www.mycobank.org.
- ^ Samson, ed. by Robert A.; Pitt, John I. (2000). Integration of modern taxonomic methods for penicillium and aspergillus classification. Amsterdam: Harwood Acad. Publ. ISBN 978-9-058-23159-8.
{{cite book}}:|first1=has generic name (help) - ^ "Aspergillus microcysticus Taxon Passport - StrainInfo". www.straininfo.net.
- ^ "Aspergillus". www.uniprot.org.
- ^ Heberle, Wolfgang (1 January 1974). "Asposterol, ein antibiotikum aus aspergillus microcysticus; unt…" (in German).
{{cite journal}}: Cite journal requires|journal=(help) - ^ Brossi, Arnold, ed. (1991). The Alkaloids, 40. Burlington: Elsevier. ISBN 978-0-080-86564-5.
- ^ Dictionary of natural products (1. ed.). London [u.a.]: Chapman & Hall. 1994. ISBN 978-0-412-46620-5.
- ^ Betina, Vladimír, ed. (1993). Chromatography of mycotoxins techniques and applications. Amsterdam: Elsevier. ISBN 978-0-080-85862-3.
- ^ Keller-Schierlein, Walter; Kupfer, Ernst (17 July 1979). "Stoffwechselprodukte von Mikroorganismen. 186. Mitteilung. Über die Aspochalasine A, B, C und D". Helvetica Chimica Acta. 62 (5): 1501–1524. doi:10.1002/hlca.19790620516.
Further reading
- Machida, edited by Masayuki; Gomi, Katsuya (2010). Aspergillus : molecular biology and genomics. Wymondham, Norfolk, UK: Caister Academic. ISBN 978-1-904-45553-0.
{{cite book}}:|first1=has generic name (help) - Gunstone, senior reporter F.D. (1981). Aliphatic and related natural product chemistry. London: Royal Society of Chemistry. ISBN 978-0-851-86652-9.
- Samson, R.A.; Peterson, S.W.; Frisvad, J.C.; Varga, J. (June 2011). "New species in Aspergillus section Terrei". Studies in Mycology. 69 (1): 39–55. doi:10.3114/sim.2011.69.04. PMC 3161753. PMID 21892242.